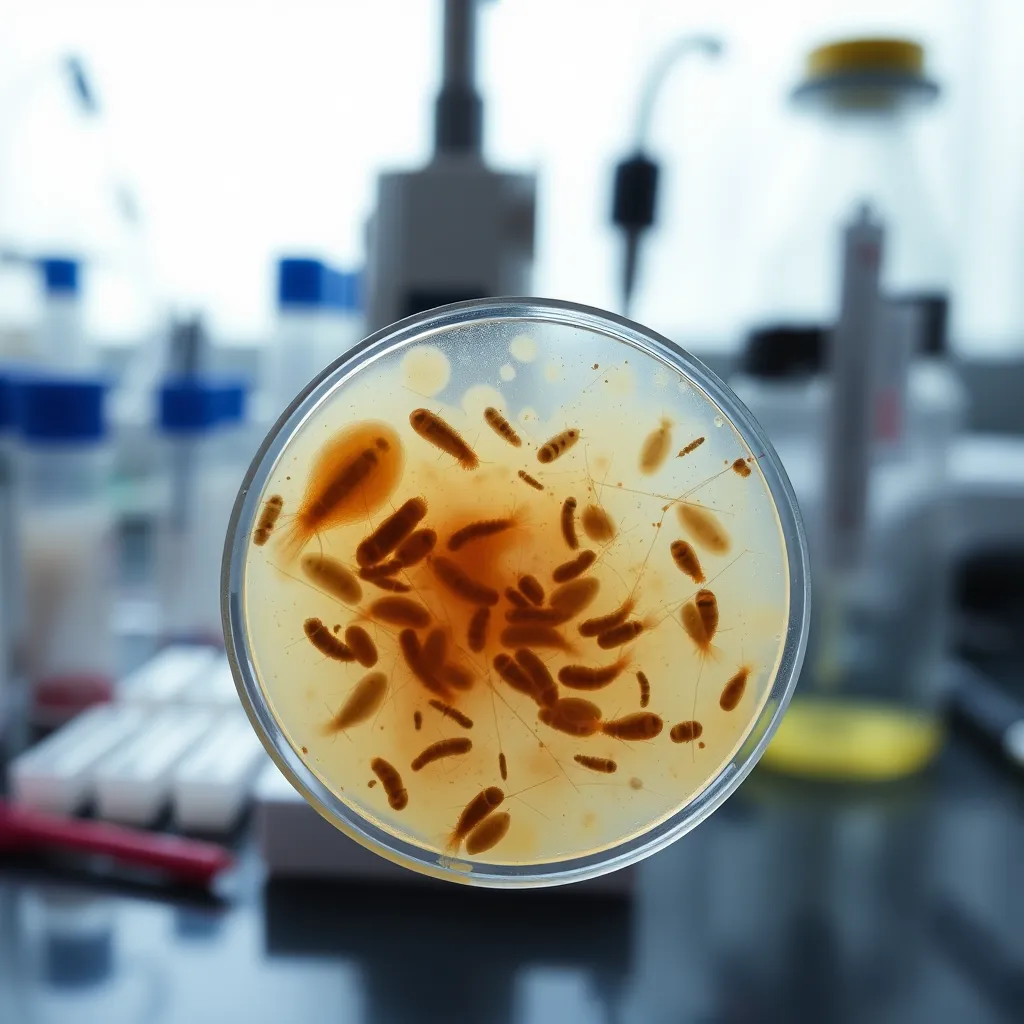
Pasożyty u dzieci – jak je wykryć i skutecznie leczyć?

Zdrowie naszych dzieci jest dla nas priorytetem, dlatego tak ważne jest, abyśmy potrafili rozpoznać i odpowiednio reagować na zagrożenia zdrowotne, takie jak pasożyty. Pasożyty to organizmy, które mogą wywołać wiele nieprzyjemnych objawów, a ich obecność w organizmie dziecka bywa trudna do zdiagnozowania bez odpowiedniej wiedzy i narzędzi. W artykule tym omówimy, jak rozpoznać różne rodzaje pasożytów u dzieci oraz jakie metody leczenia są najskuteczniejsze. Zrozumienie problemu i odpowiednie reagowanie może znacznie poprawić komfort życia małego pacjenta i jego rodziny.
Pasożyty u dzieci – objawy i diagnoza
Rozpoznanie pasożytów u dzieci może być wyzwaniem, ponieważ objawy często są niespecyficzne i mogą przypominać inne dolegliwości. Najczęstsze objawy to niespokojny sen, swędzenie w okolicy odbytu, utrata apetytu, bóle brzucha oraz nudności. Objawy te mogą sugerować obecność owsików, ale mogą także wskazywać na inne problemy zdrowotne. W przypadku podejrzenia pasożytów, ważne jest, aby nie bagatelizować tych objawów i jak najszybciej skonsultować się z lekarzem, który zleci odpowiednie testy diagnostyczne.
Różne pasożyty mogą wywoływać różne symptomy. Na przykład, w przypadku lambliozy, dziecko może doświadczać przewlekłych bólów brzucha i biegunki. Natomiast glistnica często przebiega z bólami brzucha i czasami kaszlem, co jest efektem wędrówek larw przez organizm. Rodzice powinni być czujni i obserwować, czy u dziecka nie pojawiają się objawy mogące sugerować infekcję pasożytniczą, a także być świadomi, że niektóre zarażenia mogą przebiegać bezobjawowo.
Jak wykryć owsiki u dzieci?
Owsiki to jedne z najczęściej występujących pasożytów u dzieci, które mogą powodować szereg nieprzyjemnych objawów. Aby potwierdzić ich obecność, stosuje się prosty test polegający na pobraniu wymazu z okolicy odbytu za pomocą taśmy celofanowej. Test ten najlepiej wykonywać rano, zanim dziecko się umyje, co zwiększa jego wiarygodność. Jeśli wynik jest dodatni, zaleca się leczenie całej rodziny, ponieważ owsiki łatwo się rozprzestrzeniają wśród domowników.
Kluczowe jest, aby w trakcie leczenia owsicy szczególną uwagę zwrócić na higienę. Regularne mycie rąk, zmiana pościeli i piżam oraz dokładne sprzątanie domu mogą znacznie zmniejszyć ryzyko ponownego zarażenia. Owsiki są wyjątkowo zaraźliwe, dlatego tak ważna jest wspólna walka wszystkich członków rodziny z tym problemem, aby skutecznie wyeliminować pasożyty z otoczenia.
Metody diagnozowania lambliozy
Lamblioza to kolejna często występująca infekcja pasożytnicza u dzieci, wywołana przez pierwotniaka Giardia lamblia. Diagnoza lambliozy opiera się na badaniu stolca w kierunku obecności antygenów Giardia. Badanie to jest nieinwazyjne i dość dokładne, co pozwala na szybką identyfikację problemu. W przypadku potwierdzenia lambliozy, zaleca się leczenie wszystkich członków rodziny, którzy mają kontakt z zarażonym dzieckiem, aby zapobiec dalszemu rozprzestrzenianiu się choroby.
Objawy lambliozy mogą być bardzo uciążliwe, a ich wystąpienie powinno skłonić rodziców do szybkiej reakcji. W niektórych przypadkach lamblioza może prowadzić do przewlekłych problemów trawiennych, co dodatkowo podkreśla konieczność podjęcia leczenia. Ważne jest również, aby po zakończeniu terapii przeprowadzić kontrolne badania, które potwierdzą, że pasożyty zostały całkowicie wyeliminowane z organizmu dziecka.
Glistnica – objawy i diagnostyka
Glistnica to choroba pasożytnicza, której przyczyną jest zarażenie glistą ludzką. Objawy glistnicy mogą obejmować bóle brzucha, nudności, a czasem także kaszel. Diagnoza glistnicy najczęściej opiera się na wykryciu jaj lub dorosłych osobników glisty w kale. Badanie to jest stosunkowo proste, a jego wyniki pozwalają na szybkie rozpoczęcie leczenia. Choć zarażony glistnicą człowiek nie stanowi bezpośredniego zagrożenia dla innych, konieczne jest podjęcie środków ostrożności, aby zapobiec zarażeniu innych osób.
W przypadku glistnicy, podobnie jak w przypadku innych pasożytów, higiena odgrywa kluczową rolę w zapobieganiu rozprzestrzeniania się choroby. Regularne mycie rąk, unikanie kontaktu z zanieczyszczonymi powierzchniami i dbanie o czystość w otoczeniu dziecka to podstawowe działania, które mogą pomóc w ograniczeniu ryzyka infekcji. Warto również zwrócić uwagę na dietę dziecka, która powinna być bogata w witaminy i składniki odżywcze wspierające układ odpornościowy.
Skuteczne leczenie pasożytów u dzieci
Leczenie pasożytów u dzieci wymaga kompleksowego podejścia, które obejmuje zarówno farmakoterapię, jak i działania profilaktyczne. Leki przeciwpasożytnicze są zazwyczaj skuteczne, ale ich wybór zależy od rodzaju pasożyta i stopnia zaawansowania infekcji. W przypadku owsików i glistnicy, leki takie jak mebendazol czy albendazol są często stosowane i dają dobre rezultaty. Leczenie powinno być prowadzone pod nadzorem lekarza, który dobierze odpowiednią dawkę i czas trwania terapii.
Równocześnie z leczeniem farmakologicznym, nie można zapominać o działaniach profilaktycznych, które zmniejszają ryzyko ponownego zarażenia. Edukacja dzieci na temat higieny osobistej, utrzymanie czystości w domu oraz monitorowanie stanu zdrowia wszystkich domowników to kluczowe elementy skutecznej walki z pasożytami. Regularne kontrole lekarskie i badania kontrolne również odgrywają ważną rolę w zapewnieniu, że pasożyty zostały skutecznie wyeliminowane z organizmu dziecka.
Podsumowując, pasożyty u dzieci mogą być źródłem wielu problemów zdrowotnych, ale dzięki odpowiedniej diagnozie i leczeniu można skutecznie im zapobiegać i eliminować je z organizmu. Ważne jest, aby rodzice byli świadomi objawów, metod diagnozy i leczenia różnych rodzajów pasożytów, co pozwoli im na szybkie i skuteczne reagowanie na infekcje. Dbałość o higienę i regularne kontrole zdrowia to najlepsza strategia w walce z pasożytami. Dzięki temu możemy zapewnić naszym dzieciom zdrowie i komfort codziennego życia.
Co warto zapamietać?:
- Pasożyty u dzieci mogą wywoływać niespecyficzne objawy, takie jak niespokojny sen, swędzenie w okolicy odbytu, utrata apetytu, bóle brzucha i nudności. W przypadku podejrzenia pasożytów konieczna jest wizyta u lekarza w celu diagnozy.
- Owsiki i lamblie to jedne z najczęstszych pasożytów u dzieci. Diagnoza owsików polega na teście z taśmą celofanową, zaś lamblioza wykrywana jest przez badanie stolca na obecność antygenów Giardia.
- Glistnica objawia się bólami brzucha, nudnościami i kaszlem, a diagnozowana jest poprzez wykrycie jaj lub dorosłych glist w kale.
- Leczenie pasożytów obejmuje farmakoterapię (np. mebendazol, albendazol) oraz działania profilaktyczne, takie jak edukacja na temat higieny, utrzymanie czystości w domu i monitorowanie zdrowia domowników.
- Zapobieganie i leczenie pasożytów wymaga kompleksowego podejścia, w tym regularnych kontroli lekarskich i badań kontrolnych, by zapewnić skuteczne wyeliminowanie pasożytów z organizmu dziecka.